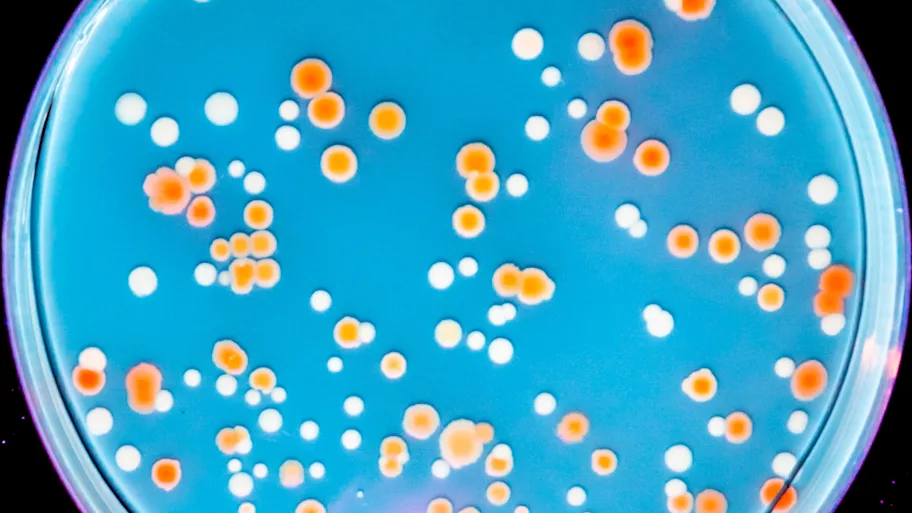

- Science News
- Featured news
- Getting out of hot water: does mobile DNA help?
Getting out of hot water: does mobile DNA help?

Many researchers assume that the first life forms on Earth evolved in hot springs — but how did these extremophiles evolve to colonize the Earth’s more hospitable places? Image: Shutterstock
The first DNA analysis of an ammonia-oxidizing microbe gives clues to how its extremophilic ancestor moved from hot springs to conquer the world.
— By Emma Duncan
Extremophiles – hardy organisms living in places that would kill most life on Earth – provide fascinating insights into evolution, metabolism and even possible extraterrestrial life. A new study provides insights into how one type of extremophile, a heat-loving microbe that uses ammonia for energy production, may have been able to make the transition from hot springs to more moderate environments across the globe. The first-ever analysis of DNA of a contemporary heat-loving, ammonia-oxidizing organism, published in open-access journal Frontiers in Microbiology, reveals that evolution of the necessary adaptations may have been helped by highly mobile genetic elements and DNA exchange with a variety of other organisms.
Most extremophiles are microorganisms — and many of the most extreme are archaea, an ancient group of single-celled organisms intermediate between the other two domains of life, bacteria and eukaryotes. Different archaea lineages are specialized to different extreme environments, including scalding hot springs, incredibly salty lakes, sunless deep-sea trenches and frigid Antarctic deserts. Only one branch, Thaumarchaeota, has managed to very successfully colonize the Earth’s more hospitable places — but scientists don’t know why.
“Thaumarchaeota are found in very large numbers in virtually all environments, including the oceans, soils, plant leaves and the human skin,” says Professor Christa Schleper from the University of Vienna, Austria, who guided and initiated the study. “We want to know what their secret is: billions of years ago, how did they adapt from hot springs, where it seems all archaea evolved, to more moderate habitats?”
As a starting point to answer this question, Professor Schleper and her team isolated a Thaumarchaeota species from a hot spring in Italy then sequenced and analyzed its genome. This represents the first genome analysis of the Nitroscaldus lineage — a subgroup of heat-loving Thaumarchaeota that get their energy by oxidizing ammonia into nitrite.
The analysis revealed that the organism, Candidatus Nitrosocaldus cavascurensis, seems to represent the closest-related lineage to the last common ancestor of all Thaumarchaeota. Intriguingly, it has highly mobile DNA elements and seems to have frequently exchanged DNA with other organisms — including other archaea, viruses and possibly even bacteria.
The ability to exchange genetic material could help this archaeon to rapidly evolve. “This organism seems prone to lateral gene transfer and invasion by foreign DNA elements,” says Professor Schleper. “Such mechanisms may have also helped the ancestral lines of Thaumarchaeota to evolve and eventually radiate into moderate environments — and N. cavascurensis may still be evolving through genetic exchange with neighboring organisms in its hot spring.”
Many researchers assume that the first life forms on Earth evolved in hot springs. Further studies of this thermophilic archaeon might help identify general mechanisms that enabled the first living cells, both bacteria and archaea, to conquer the world.
Original research article: Candidatus Nitrosocaldus cavascurensis, an Ammonia Oxidizing, Extremely Thermophilic Archaeon with a Highly Mobile Genome
Corresponding author: Christa Schleper
REPUBLISHING GUIDELINES: Open access and sharing research is part of Frontier’s mission. Unless otherwise noted, you can republish articles posted in the Frontiers news blog — as long as you include a link back to the original research. Selling the articles is not allowed.